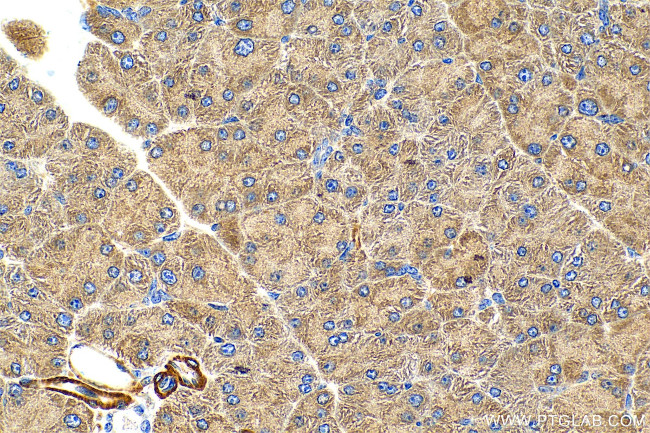
RIT2 Antibody in Immunohistochemistry (Paraffin) (IHC (P))

Search
Proteintech
RIT2 Polyclonal Antibody
{{$productOrderCtrl.translations['antibody.pdp.commerceCard.promotion.promotions']}}
{{$productOrderCtrl.translations['antibody.pdp.commerceCard.promotion.viewpromo']}}
{{$productOrderCtrl.translations['antibody.pdp.commerceCard.promotion.promocode']}}: {{promo.promoCode}} {{promo.promoTitle}} {{promo.promoDescription}}. {{$productOrderCtrl.translations['antibody.pdp.commerceCard.promotion.learnmore']}}
产品信息
12473-1-AP
种属反应
宿主/亚型
分类
类型
抗原
偶联物
形式
浓度
规格
纯化类型
保存液
内含物
保存条件
运输条件
产品详细信息
Immunogen sequence: MEVENEASCS PGSASGGSRE YKVVMLGAGG VGKSAMTMQF ISHQFPDYHD PTIEDAYKTQ VRIDNEPAYL DILDTAGQAE FTAMREQYMR GGEGFIICYS VTDRQSFQEA AKFKELIFQV RHTYEIPLVL VGNKIDLEQF RQVSTEEGLS LAQEYNCGFF ETSAALRFCI DDAFHGLVRE IRKKESMPSL MEKKLKRKDC LWKKLKGSLK KKRENMT
靶标信息
Ras-like without CAAX 2 (RIT2) is a gene located on chromosome 18q12.1, encoding a member of the Ras superfamily of small GTPases. RIT2 is primarily expressed in neuronal tissues, where it plays a crucial role in intracellular signaling pathways that regulate neuronal differentiation, survival, and plasticity. Functionally, RIT2 is involved in neurotrophic factor signaling, contributing to the maintenance and function of the nervous system. This protein interacts with various downstream effectors to influence cellular processes such as growth factor response and neuronal signaling dynamics. Alterations or mutations in RIT2 have been associated with neurological disorders, including Parkinson's disease, implicating its role in neurodegenerative processes. Research into RIT2 aims to elucidate its precise mechanisms in neural signaling and its potential as a therapeutic target for treating neurodegenerative diseases.
仅用于科研。不用于诊断过程。未经明确授权不得转售。
篇参考文献 (0)
生物信息学
蛋白别名: GTP-binding protein Rit2; GTP-binding protein Roc2; RAS-like protein expressed in neuron; Ras-like protein expressed in neurons; Ras-like without CAAX 1; Ras-like without CAAX protein 2; Ric-like, expressed in neurons; small GTP binding protein; unnamed protein product
基因别名: RIBA; RIN; Rit1; RIT2; ROC2
UniProt ID: (Human) Q99578, (Rat) Q5BJQ5, (Mouse) P70425
Entrez Gene ID: (Human) 6014, (Rat) 291713, (Mouse) 19762